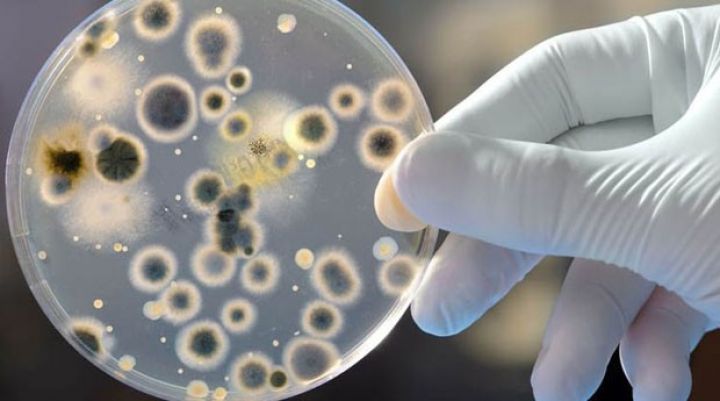
AQTA xaricdə təhsil almış gəncləri yüksək məvaciblə işə dəvət edir

AQTA xaricdə təhsil almış gəncləri yüksək məvaciblə işə dəvət edir
Azərbaycan Qida Təhlükəsizliyi İnstitutu xarici ölkələrdə təhsil almış gəncləri yüksək məvaciblə işə dəvət edir.
Azərbaycan Qida Təhlükəsizliyi İnstitutunda və qurumun regional sınaq laboratoriyalarında bioloq, mikrobioloq, virusoloq, kimyaçı, aqronom, həkim laborant, sanitariya həkimi, epidemioloq, toksikoloq, molekulyar bioloq, torpaqşünaslıq, iqtisadiyyat, maliyyə və mühasibat uçotu, idarəetmə üzrə mütəxəssis, baytar həkimi və fitosanitar mütəxəssis ixtisasları üzrə (yaş həddi 23- 50) yüksək məvacibli vakant vəzifələrin tutulması üçün müsahibə elan olunur.
YAPI KREDİDƏN 3 FAİZ ENDİRİMLƏ KREDİT!
Müraciət etmək istəyən şəxslər 19.11.2018-ci il tarixindən 24.12.2018-ci il tarixinədək Qida Təhlükəsizliyi İnstitutuna müraciət edə bilərlər.
Ünvan: Bakı şəh., S.S.Axundov küç. 73c. Əlaqə nömrəsi: (012) 565-12-82 (573), (530). email: [email protected]
Müştərilərin xəbərləri
SON XƏBƏRLƏR
- 1 ay sonra
- 2 həftə sonra
- 2 gün sonra
-

-
15 saat sonra
Yay mövsümü üçün iş: Supermarketlər şəbəkəsi işə qəbul elan etdi
- 13 saat əvvəl
-
1 gün əvvəl
Samir Rzayev: Naxçıvan reyslərində dəyişikliklər uçuş təhlükəsizliyi nəzərə alınaraq keçirilir
- 1 gün əvvəl
-
1 gün əvvəl
Rusiya AZAL təyyarəsinin vurulması ilə bağlı yaxın zamanda kompensasiya köçürəcək
-
1 gün əvvəl
15 il əvvəl bazardan çəkilmişdi, 100 yeni restoranla geri qayıdır
-
1 gün əvvəl
2 milyard 428 milyon dollarlıq ixracla Türkiyə tarixinin gündəlik ixrac rekordu yenilənib
- 1 gün əvvəl
- 1 gün əvvəl
Son Xəbərlər

Azvak.az-da yeni iş elanları

55 manatdan bank səhmdarı olmaq fürsəti: SON 21 GÜN

Bank sərfəli şərtlərlə əmanət qəbuluna davam edir

Mayın 25-də gözlənilən hava şəraiti

AZAL-ın sədrindən aviabiletlərin qiymətləri barədə açıqlama

2 milyard 428 milyon dollarlıq ixracla Türkiyə tarixinin gündəlik ixrac rekordu yenilənib

Yapon avtomobili Nissan Magnite - CƏMİ 27 900 MANATA
Ən çox oxunanlar

ABŞ və İran atəşkəsin 60 gün uzadılmasını müzakirə edir

Ödənişlər qeyri-həyat sığortası üzrə 17 %-dən çox, icbari sığortalar üzrə 21 %-dən çox artıb

Azərbaycana düyü idxalı 18,3% azalıb

Bakının 64 yaşayış məntəqəsinin kanalizasiya sistemi qurulacaq, 30 əsas küçə və prospektində yeni kollektorlar inşa ediləcək

Azərbaycan neftinin son qiyməti

Mayın 24-nə olan hava proqnozu - 28 dərəcəyədək isti olacaq

“Finex Kredit” BOKT-da ciddi azalmalar baş verib, 1 milyon 373 min manat zərərə düşüb










.jpg)








.jpg)





